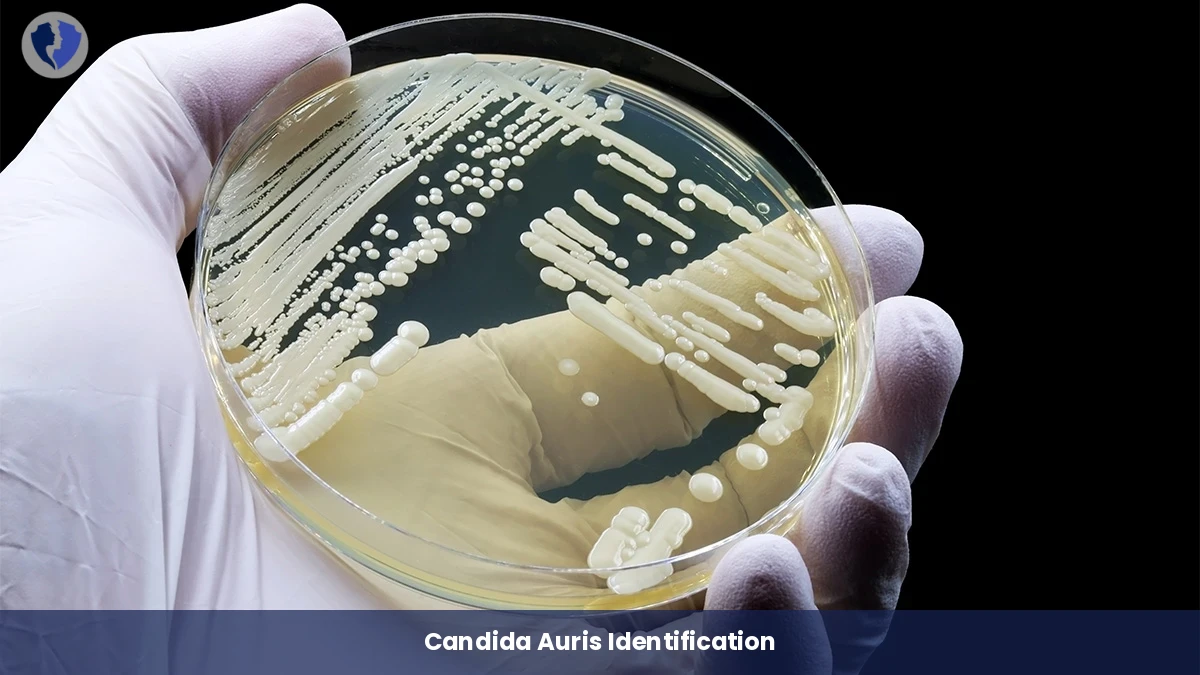
Candida Auris Identification

Service Details
Candida Auris Identification
In this test, a clinical sample (from blood, urine, wounds, respiratory swabs, or others) is cultured on special fungal media, then suspicious colonies are isolated. Advanced biochemical (e.g., MALDI-TOF MS) and/or molecular (PCR) techniques are used to accurately identify the fungus to the species level, focusing on distinguishing Candida auris from other Candida species. The test also includes Antifungal Susceptibility Testing (AST) to determine its drug resistance profile.